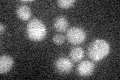
YDR140W
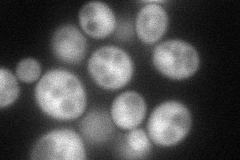
YDR140W
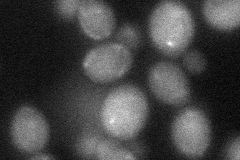
YDR140W

View description
S-adenosylmethionine-dependent methyltransferase of the seven beta-strand family; subunit of complex with Trm112p that methylates translation release factor Sup45p (eRF1) in the ternary complex eRF1-eRF3-GTP; similar to E.coli PrmC
Localization:
Intensity:
Fold change:
Significance:
-
C’ GFP library in SD
below threshold17.07 -
N' NOP1pr-GFP in SD
cytosol69.1181 -
N' TEF2pr-mCherry in SD

cytosol67.903 -
N' NATIVEpr-GFP in SD

cytosol39.8681 -
N' TEF2pr-VC and Cyto-VN in SD
cytosol35.8603 -
C’ GFP library in SD+DTT

cytosol17.561.02No -
C’ GFP library in SD+H2O2

cytosol14.830.86No -
C’ GFP library in Starvation Media

cytosol14.540.85No -
C’ GFP library on the background of Pup2-DaMP

below threshold -
C’ GFP library on the background of CCT mutant

below threshold17.51971.0254No
